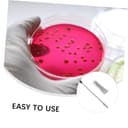
Thumbnail 7
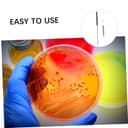
Thumbnail 8

🔬 Unleash Your Inner Scientist with Every Loop!
The Balacoo 1 Set Reusable Inoculating Loop Holders feature durable nichrome needle tips, designed for efficient inoculation in various settings, including laboratories and classrooms. Lightweight and compact, these tools allow for quick, one-handed operation, making them ideal for transferring samples with precision.
| Units | 1.00 count |
| Brand | Balacoo |
| Country of origin | China |
Trustpilot
5 days ago
2 days ago
1 month ago
2 months ago